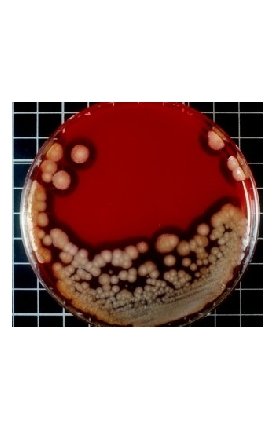
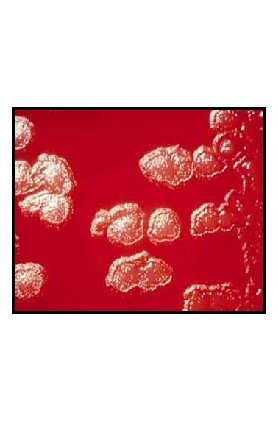

Case 1 A patient with a peptic ulcer

- Slides: 75
Case (1)
• A patient with a peptic ulcer was admitted to the hospital and a gastric biopsy was preformed. The tissue was cultured on chocolate agar incubated in a microaerophilic environment at 37ºC for 5 to 7 days.
• At 5 days of incubation, colonies appeared on the plate and they were curved and after the staining they were gram-negative rods:
• These colonies were Oxidase-positive:
The Questions 1. Name the most likely causative agent. 2. Mention other media which are suitable for growth of this organism? 3. What are other methods to confirm diagnosis?
Case (2)
• A patient was hospitalized after an automobile accident. The wounds became infected and the patient was treated with ampicillin.
• Five days after antibiotic therapy was initiated, the patient developed severe diarrhea and pseudomembranous enterocolitis, the micro lab cultured the stool and gram stain was performed, and showed spore forming grampositive rods:
The Questions 1. Antibiotic-associated diarrhea and the most serious pseudomembranous enterocolitis can be caused by which micro-organism? 2. Enumerate the virulence factors of this microorganism?
3. How can you prevent the occurrence of this infection? 4. Mention the media which are suitable for growth of this organism? 5. Mention the confirmatory tests for diagnosis of this case.
6. Name another antibiotic that can cause this disease.
Case (3)
• A patient been rushed immediately into the emergency room unconscious, not breathing, her friends said that she complained of double vision and suffered with problems in breathing soon after eating canned sausage:
• The gram stain showed gram positive rods with subterminal spores:
Electron microscope image
The Questions 1. These are symptoms of food poising caused by? 2. Enumerate the virulence factors of this microorganism? 3. How can you prevent the occurrence of this infection?
4. Mention the media which are suitable for growth of this organism? 5. Name others tests used for confirming this diagnosis.
Case (4)
• A young adult farmer who raises sheep and goats presents with symptom of fever. History suggests that the fever rises and falls (shows a pattern).
• Laboratory diagnosis shows on gram stain, gram-negative rods:
• And on culture:
The Questions 1. Name the causative agent. 2. Name other members of this group. 3. Mention diagnostic tests witch can be used in diagnosis of this case.
4. Mention drugs used in treatment of this case.
Case (5)
• A young lady having a a cough with thick, cloudy, bloody mucus from the lungs (sputum) for more than 2 weeks. • Fever, chills, and night sweats. • Fatigue and weakness.
• The doctor performed the Xray below:
• And a sputum sample was taken to the microbiology lab. and was processed in a negative pressure lab. with a high level of precautions.
The direct smear under the fluorescent microscope showed small rods: Under the light microscope:
An Electronic Microscope Image
The Questions 1. These symptoms are caused by? 2. Enumerate the virulence factors of this microorganism? 3. How can you prevent the occurrence of this infection? 4. Mention drugs used in treatment of this case.
Case (6)
• A 25 years old patient complained of having a Vaginal itching that is often severe, with vaginal discharge that is usually white, curd like, and odorless. • Red, irritated skin around the opening to the vagina (labia). • Pain while urinating when urine touches irritated skin.
On the culture:
The microorganism under the microscope:
• Symptoms of a vaginal infection are more likely to occur during the week before a menstrual period. • The doctor decided to perform a vaginal swab.
The Questions 1. Name the most likely causative agent. 2. Mention other media which are suitable for growth of this organism? 3. What are other methods to confirm diagnosis? 4. Mention other diseases caused by this organism.
Case (7)
• A group of students ate turkey sandwiches prepared in the cafeteria. After 8 hours some of them experienced vomiting, abdominal pains and the others had diarrhea after 12 hours.
• stool and vomit samples ware sent to The Microbiology Lab. and after 24 hour of incubation culture showed large colonies with a rough edge.
Spore staining to the organ showed the following under the microscope:
The microorganism image by electron microscope:
The Questions 1. These symptoms are caused by? 2. Enumerate the virulence factors of this microorganism? 3. How can you prevent the occurrence of this infection? 4. Mention the best treatment for this case.
Case (8)
• A farmer who works with goat and sheep presented to the clinic with a black necrotic escar. He states that the lesion started as a painless papule.
• The doctor took a swab from the papules and sent it to The Microbiology Lab, for microscopic diagnosis and culture. After 24 hour of incubating the blood agar plate, there were a growth showing large colonies has rough edge growing on the blood agar, non -hemolytic. Also “medusa head” were detected on nutrient agar.
• Gram stain preparation from the culture showed large grampositive bacilli with central spore:
The Questions 1. Name the most likely causative agent. 2. What are the virulence factors? 3. Enumerate other confirmatory tests? 4. Mention other diseases caused by this organism. 5. What is the drug of choice used in treating this infection?
Case (9)
• A patient presents to the ER unit suffering from these symptoms: jaw stiffness, difficulty in swallowing and spasticity of the back muscles. Also, the patient was not able to sleep and alert throughout the illness.
• A clinical diagnosis was made and specimens were sent to the lab confirmation. The gram stain preparation from the culture growth on the blood agar plate, that was incubated in anaerobic incubator, showed the following:
The Questions 1. Name the most likely causative agent. 2. What are the virulence factors? 3. Enumerate other methods to confirm diagnosis? 4. Mention other diseases caused by this organism. 5. How can we treat this infection?
Virology Case (1)
• A mother called the family doctor on the phone complaining that her child suffering from these symptoms: fever, headache, sore throat, tired, and not very hungry. Also, rash appeared about 1 or 2 days after the first symptoms started.
The Questions 1. Name the most likely causative agent. 2. How is it treated? 3. How can you prevent this infection?
Virology Case (2)
• A mother brought her son to the clinic suffering from parotid inflammation (parotitis causes swelling and local pain, particularly when chewing. It can occur on one side (unilateral) or both sides (bilateral), fever, headache.
The Questions 1. Name the most likely causative agent. 2. How is it treated? 3. How can you prevent this infection?
Virology Case (3)
• A parents of young girl rushed her to the hospital suffering from symptoms: fever, cough, runny nose, red eyes and a generalized maculopapular, erythematous rash.
The Questions 1. Name the most likely causative agent. 2. How is it treated? 3. How can you prevent this infection?
• This is the most serious form of the disease; it can be fatal without respiratory support 1, 2 • Paralytic polio often begins with a fever; other symptoms, including headache, neck and back stiffness, and constipation, generally appear a few days later 1, 2 • Acute flaccid paralysis, which causes the limbs to appear loose and floppy,
• http: //www. polio. com/? fa=le arn/polio/disease#2